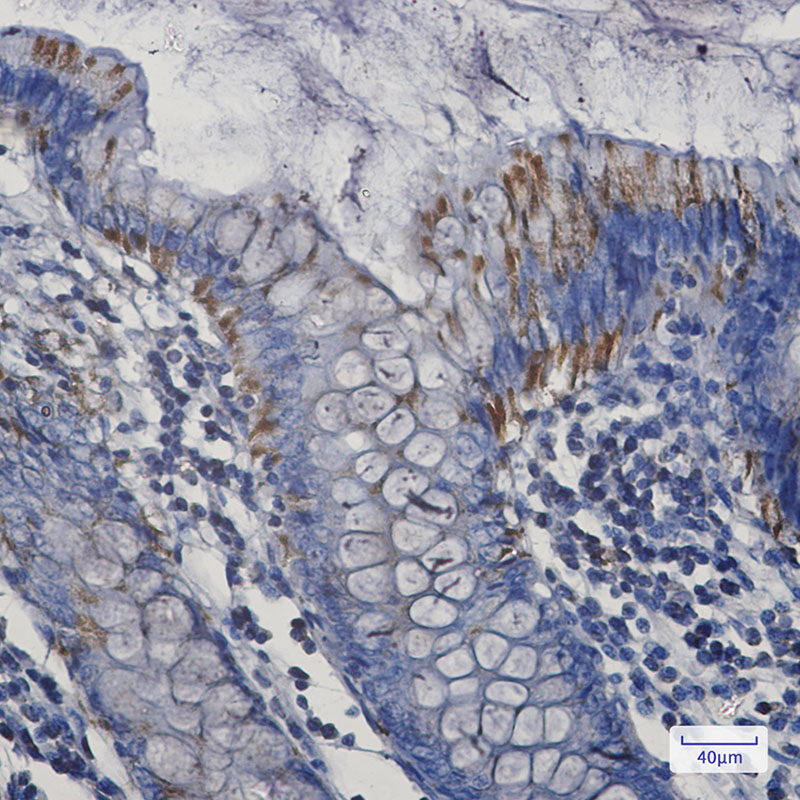

别名:BAK1; BAK; BCL2L7; CDN1; Bcl-2 homologous antagonist/killer; Apoptosis regulator BAK; Bcl-2-like protein 7; Bcl2-L-7应用:WB,IHC,IP
反应种属:Human
规格:50μl/100μl
| Description |
|---|
| Bak is a proapoptotic member of the Bcl-2 family. This protein is located on the outer membrane of mitochondria and is an essential component for transduction of apoptotic signals through the mitochondrial pathway. Upon apoptotic stimulation, an upstream stimulator like truncated BID (tBID) induces conformational changes in Bak to form oligomer channels in the mitochondrial membrane for cytochrome c release. The release of cytochrome c to the cytosol activates the caspase-9 pathway and eventually leads to cell death. |
| Specification | |
|---|---|
| Aliases | BAK1; BAK; BCL2L7; CDN1; Bcl-2 homologous antagonist/killer; Apoptosis regulator BAK; Bcl-2-like protein 7; Bcl2-L-7 |
| Entrez GeneID | 578 |
| Swissprot | Q16611 |
| WB Predicted band size | Calculated MW: 23 kDa; Observed MW: 23 kDa |
| Host/Isotype | Rabbit IgG |
| Storage | Store at 4°C short term. Aliquot and store at -20°C long term. Avoid freeze/thaw cycles. |
| Species Reactivity | Human |
| Immunogen | A synthetic peptide of human Bak |
| Formulation | 50mM Tris-Glycine(pH 7.4), 0.15M NaCl, 40% Glycerol, 0.01% Sodium azide and 0.05% BSA |
| Application | |
|---|---|
| IP | 1/20 |
| WB | 1/500-1/1000 |
| IHC | 1/50-1/100 |
![]() |
Western blot analysis of Bak in K562, Hela lysates using Bak antibody. |
![]() |
Immunohistochemistry analysis of paraffin-embedded Human colon cancer using Bak antibody.High-pressure and temperature Sodium Citrate pH 6.0 was used for antigen retrieval. |
本公司的所有产品仅用于科学研究或者工业应用等非医疗目的,不可用于人类或动物的临床诊断或治疗,非药用,非食用。
暂无评论
本公司的所有产品仅用于科学研究或者工业应用等非医疗目的,不可用于人类或动物的临床诊断或治疗,非药用,非食用。
中文

发表回复